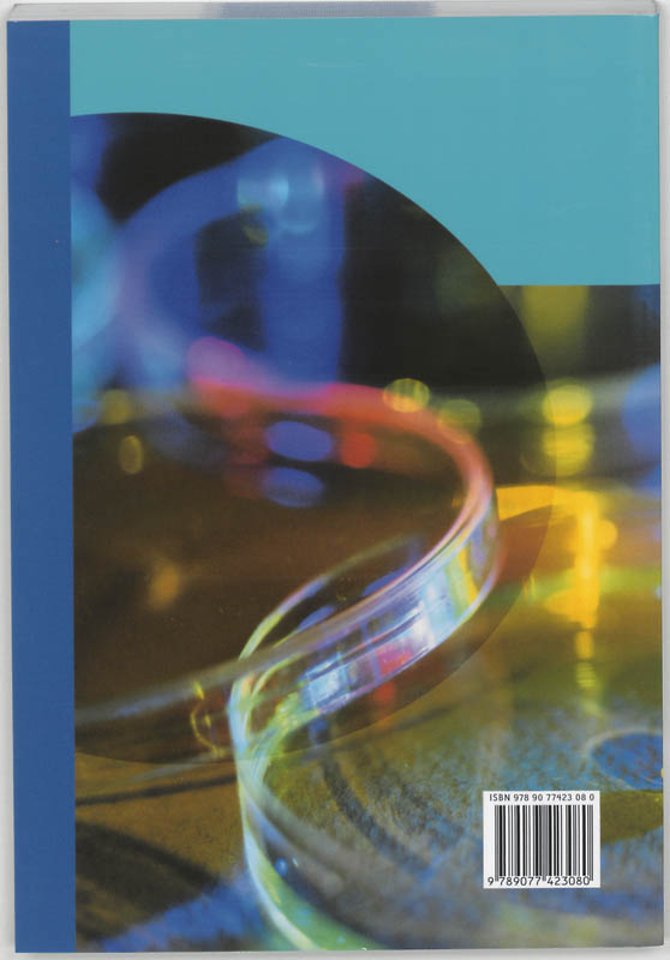
DNA een blauwdruk

DNA een blauwdruk
Samenvatting
De meeste handboeken duiken vrijwel meteen in het diepe en veronderstellen voorkennis, zodat een beginneling door de bomen het DNA-bos niet meer ziet. Dit boek dient daarom als een opstap voor meer verdergaande boeken en leidt de lezer op een begrijpelijke wijze de wereld van het DNA binnen.
Vrijwel alle onderwerpen op het brede terrein van het DNA komen aan de orde, vanaf de dubbele helix van Watson en Crick tot en met het `hermaniseren`, de ontwikkeling van transgene planten en dieren. Het uitgebreide register en de lijst van afkortingen verhogen de studiewaarde.
Specificaties
Vaak samen gekocht
Anderen die dit kochten, kochten ook
Net verschenen
Rubrieken
- aanbestedingsrecht
- aansprakelijkheids- en verzekeringsrecht
- accountancy
- algemeen juridisch
- arbeidsrecht
- bank- en effectenrecht
- bestuursrecht
- bouwrecht
- burgerlijk recht en procesrecht
- europees-internationaal recht
- fiscaal recht
- gezondheidsrecht
- insolventierecht
- intellectuele eigendom en ict-recht
- management
- mens en maatschappij
- milieu- en omgevingsrecht
- notarieel recht
- ondernemingsrecht
- pensioenrecht
- personen- en familierecht
- sociale zekerheidsrecht
- staatsrecht
- strafrecht en criminologie
- vastgoed- en huurrecht
- vreemdelingenrecht